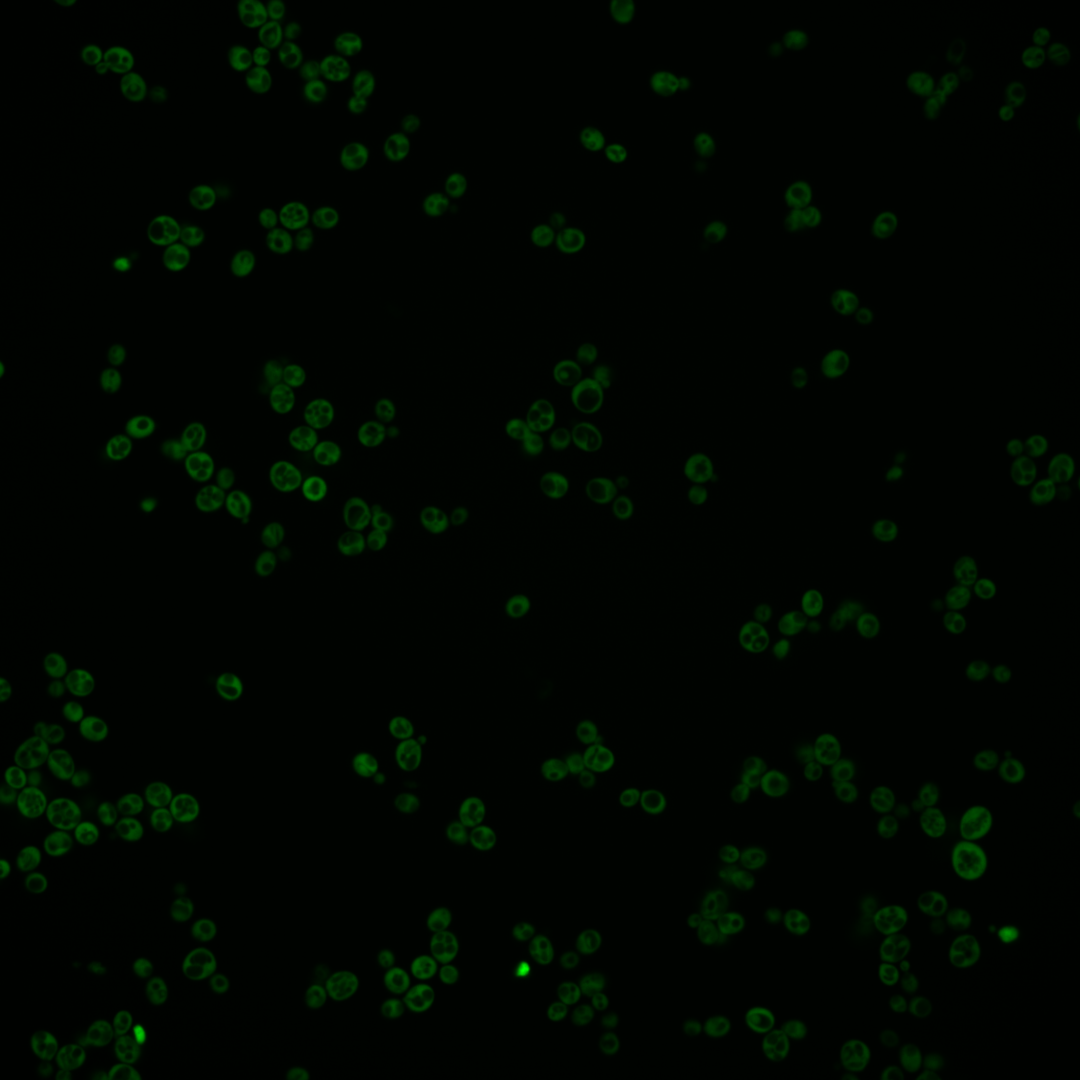
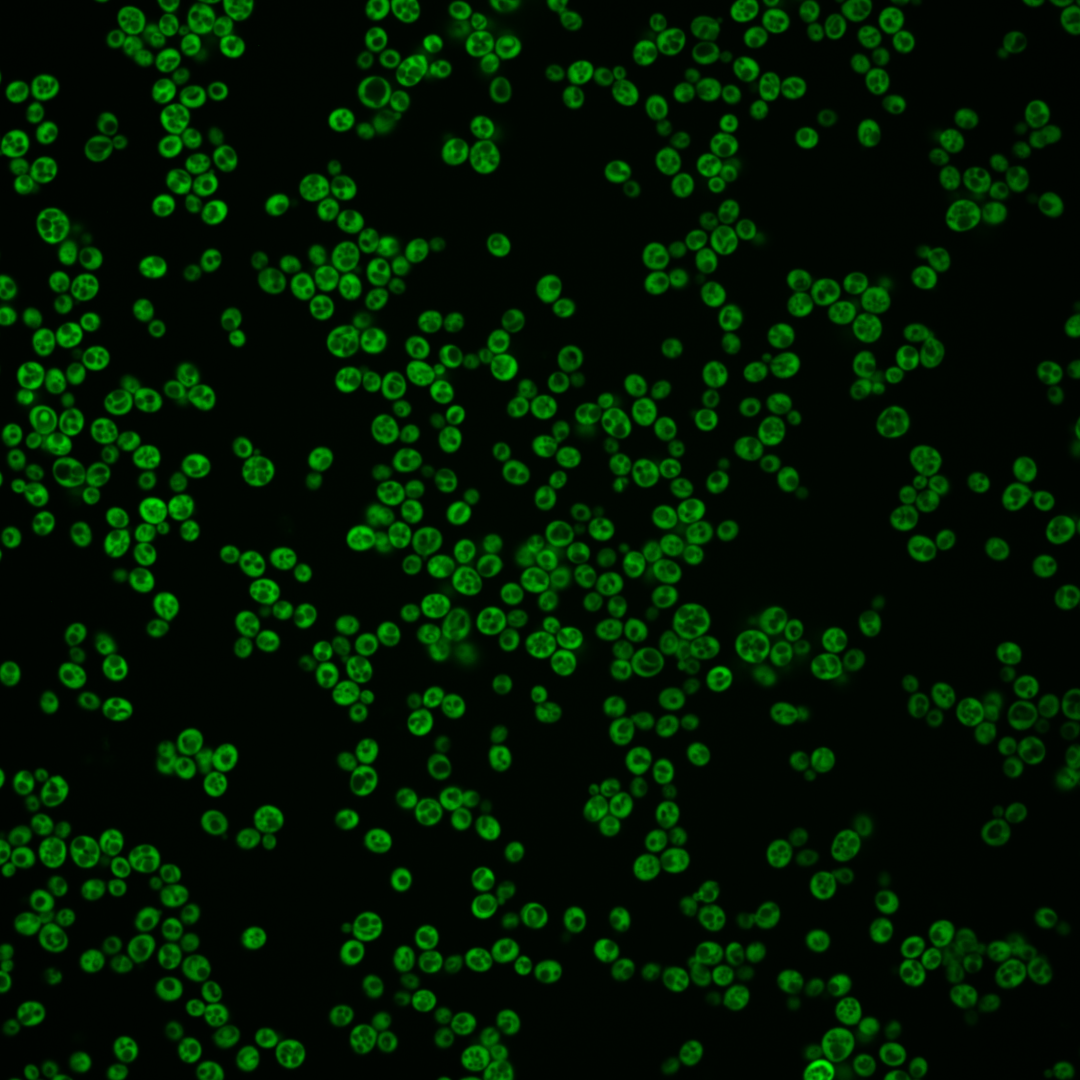
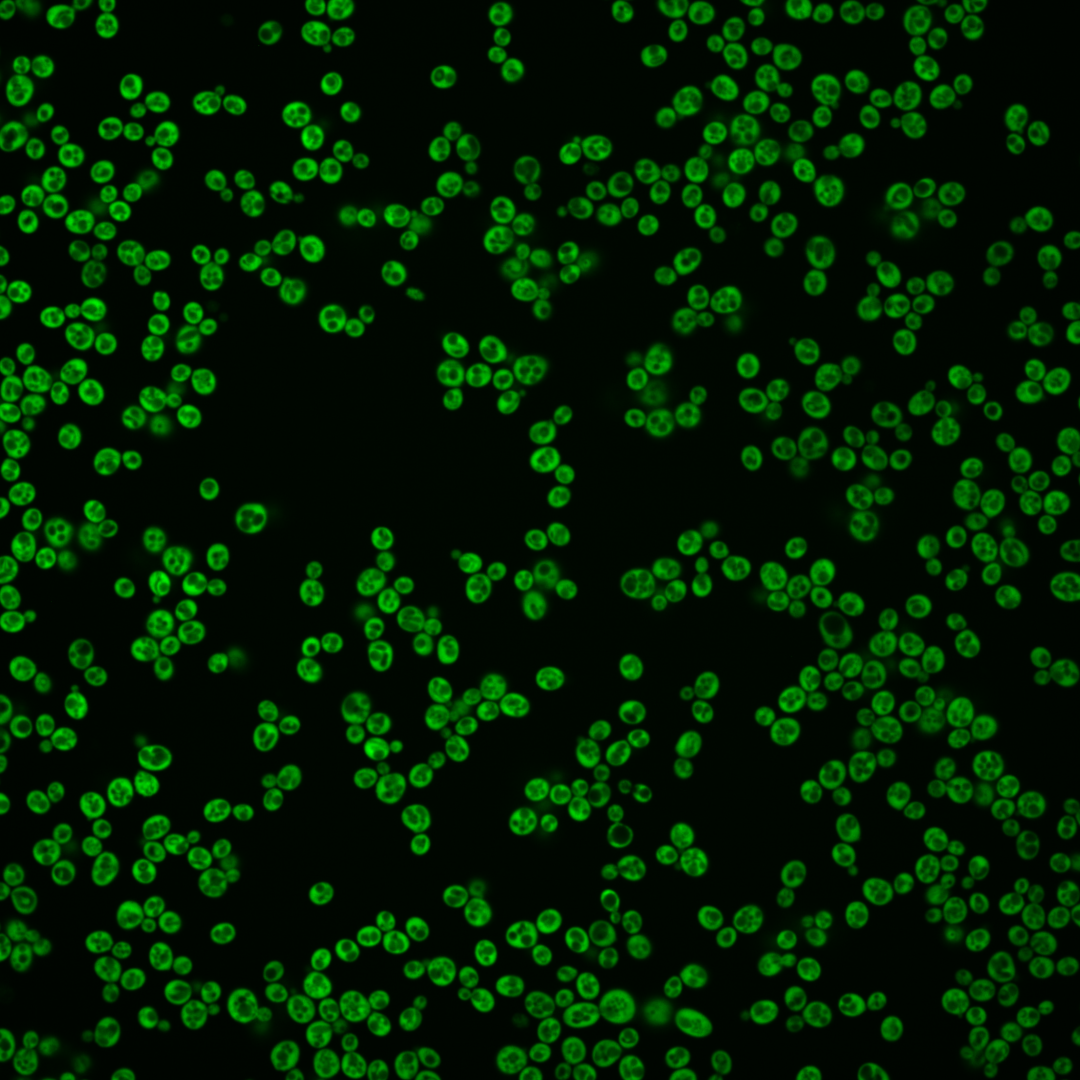
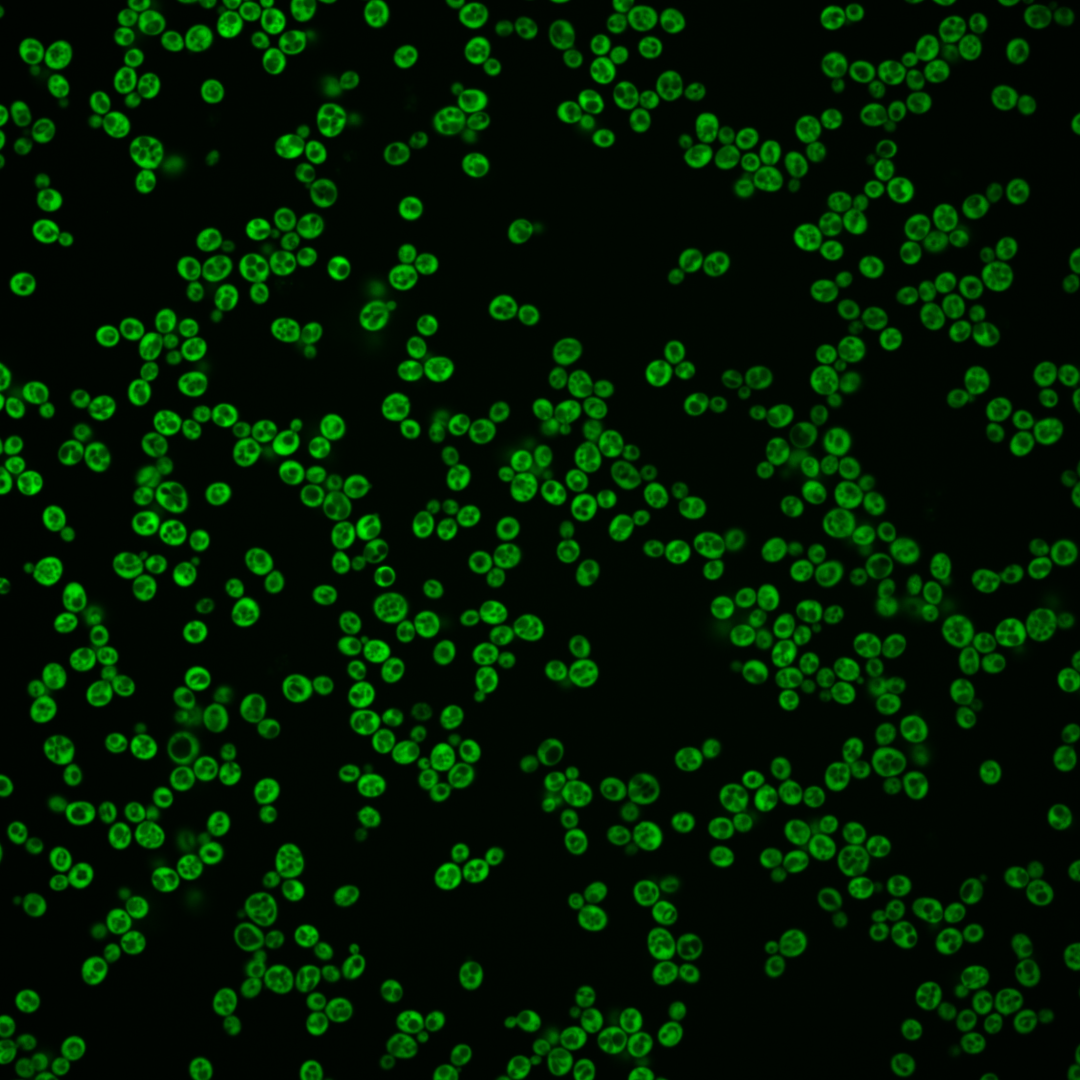

| Standard name | |
|---|---|
| Human Ortholog | |
| Description | Glutamyl-tRNA synthetase (GluRS); forms a complex with methionyl-tRNA synthetase (Mes1p) and Arc1p; complex formation increases the catalytic efficiency of both tRNA synthetases and ensures their correct localization to the cytoplasm; protein abundance increases in response to DNA replication stress |
Micrographs




















































































Sub-cellular Localization
Yeast GFP Assignment
Protein Abundance
Localization Change
External localization resources
| ensLOC | DeepLoc | |||||||||||||||||||||||
|---|---|---|---|---|---|---|---|---|---|---|---|---|---|---|---|---|---|---|---|---|---|---|---|---|
| Localization | WT1 | WT2 | WT3 | RAP60 | RAP140 | RAP220 | RAP300 | RAP380 | RAP460 | RAP540 | RAP620 | RAP700 | HU80 | HU120 | HU160 | rpd3Δ_1 | rpd3Δ_2 | rpd3Δ_3 | WT1 | WT2 | WT3 | AF100 | AF140 | AF180 |
| Cortical Patches | 0 | 0 | 0 | 0 | 1 | 5 | 15 | 11 | 20 | 32 | 32 | 38 | 0 | 0 | 0 | 0 | 0 | 0 | 0 | 0 | 0 | 0 | 0 | 0 |
| Bud | 0 | 1 | 0 | 0 | 0 | 0 | 3 | 3 | 2 | 3 | 12 | 4 | 0 | 0 | 0 | 0 | 0 | 0 | 2 | 1 | 2 | 1 | 4 | 4 |
| Bud Neck | 0 | 0 | 0 | 0 | 0 | 0 | 0 | 0 | 0 | 0 | 0 | 0 | 0 | 0 | 0 | 0 | 0 | 0 | 0 | 0 | 0 | 0 | 0 | 1 |
| Bud Site | 0 | 0 | 0 | 0 | 0 | 0 | 0 | 0 | 0 | 0 | 0 | 0 | 0 | 0 | 0 | 0 | 0 | 0 | – | – | – | – | – | – |
| Cell Periphery | 0 | 6 | 17 | 17 | 13 | 40 | 33 | 47 | 41 | 63 | 53 | 75 | 1 | 4 | 2 | 3 | 2 | 1 | 0 | 0 | 1 | 0 | 0 | 0 |
| Cytoplasm | 334 | 498 | 510 | 307 | 379 | 465 | 512 | 439 | 404 | 388 | 367 | 359 | 346 | 382 | 326 | 240 | 136 | 151 | 327 | 490 | 553 | 156 | 285 | 262 |
| Endoplasmic Reticulum | 3 | 8 | 17 | 11 | 40 | 56 | 105 | 173 | 78 | 108 | 100 | 137 | 13 | 13 | 3 | 6 | 2 | 2 | 2 | 4 | 9 | 31 | 41 | 34 |
| Endosome | 0 | 0 | 0 | 0 | 0 | 0 | 0 | 0 | 0 | 0 | 0 | 0 | 0 | 0 | 0 | 0 | 0 | 0 | 1 | 0 | 0 | 0 | 0 | 0 |
| Golgi | 0 | 0 | 1 | 3 | 1 | 2 | 3 | 9 | 13 | 8 | 18 | 10 | 0 | 0 | 0 | 0 | 1 | 1 | 0 | 0 | 0 | 2 | 0 | 1 |
| Mitochondria | 0 | 0 | 0 | 1 | 0 | 0 | 1 | 0 | 8 | 11 | 14 | 4 | 0 | 0 | 0 | 0 | 0 | 0 | 0 | 0 | 3 | 1 | 3 | 1 |
| Nucleus | 0 | 0 | 0 | 1 | 1 | 1 | 0 | 1 | 1 | 0 | 2 | 1 | 1 | 0 | 2 | 0 | 0 | 0 | 0 | 1 | 0 | 1 | 0 | 0 |
| Nuclear Periphery | 0 | 0 | 0 | 0 | 0 | 0 | 0 | 0 | 0 | 0 | 0 | 0 | 0 | 0 | 0 | 0 | 0 | 0 | 0 | 0 | 0 | 0 | 0 | 1 |
| Nucleolus | 0 | 0 | 0 | 1 | 0 | 0 | 0 | 0 | 0 | 0 | 0 | 1 | 0 | 0 | 0 | 0 | 0 | 0 | 0 | 0 | 0 | 0 | 0 | 0 |
| Peroxisomes | 0 | 0 | 0 | 0 | 0 | 0 | 0 | 0 | 0 | 0 | 0 | 0 | 0 | 0 | 0 | 0 | 0 | 0 | 0 | 0 | 0 | 0 | 0 | 0 |
| SpindlePole | 0 | 0 | 0 | 0 | 0 | 0 | 0 | 0 | 0 | 0 | 0 | 0 | 0 | 0 | 0 | 0 | 0 | 0 | 0 | 0 | 0 | 0 | 0 | 0 |
| Vac/Vac Membrane | 0 | 1 | 4 | 3 | 2 | 4 | 1 | 12 | 4 | 8 | 28 | 10 | 2 | 2 | 1 | 2 | 0 | 4 | 0 | 7 | 4 | 4 | 5 | 8 |
| Unique Cell Count | 337 | 507 | 534 | 327 | 423 | 548 | 637 | 638 | 524 | 553 | 564 | 562 | 361 | 395 | 332 | 243 | 139 | 154 | 338 | 510 | 579 | 203 | 348 | 317 |
| Labelled Cell Count | 337 | 514 | 549 | 344 | 437 | 573 | 673 | 695 | 571 | 621 | 626 | 639 | 363 | 401 | 334 | 251 | 141 | 159 | 338 | 510 | 579 | 203 | 348 | 317 |
Yeast GFP Assignment
Protein Abundance
| Screen | WT1 | WT2 | WT3 | RAP60 | RAP140 | RAP220 | RAP300 | RAP380 | RAP460 | RAP540 | RAP620 | RAP700 | HU80 | HU120 | HU160 | rpd3Δ_1 | rpd3Δ_2 | rpd3Δ_3 | AF100 | AF140 | AF180 |
|---|---|---|---|---|---|---|---|---|---|---|---|---|---|---|---|---|---|---|---|---|---|
| Mean Cell GFP Intensity (1e-4) | 70.8 | 70.6 | 53.2 | 48.8 | 46.7 | 41.7 | 39.5 | 39.5 | 36.0 | 33.2 | 29.3 | 34.1 | 66.8 | 68.2 | 63.3 | 90.0 | 97.0 | 79.4 | 59.9 | 66.1 | 71.5 |
| Std Deviation (1e-4) | 17.0 | 15.0 | 12.9 | 14.4 | 11.6 | 10.5 | 9.5 | 9.4 | 9.0 | 7.9 | 7.0 | 8.2 | 16.9 | 17.0 | 17.8 | 26.1 | 29.1 | 28.5 | 16.3 | 19.7 | 21.6 |
| Intensity Change (Log2) | – | – | – | -0.13 | -0.19 | -0.35 | -0.43 | -0.43 | -0.56 | -0.68 | -0.86 | -0.64 | 0.33 | 0.36 | 0.25 | 0.76 | 0.87 | 0.58 | 0.17 | 0.31 | 0.43 |
Localization Change
| Localization | RAP60 | RAP140 | RAP220 | RAP300 | RAP380 | RAP460 | RAP540 | RAP620 | RAP700 | HU80 | HU120 | HU160 | rpd3Δ_1 | rpd3Δ_2 | rpd3Δ_3 |
|---|---|---|---|---|---|---|---|---|---|---|---|---|---|---|---|
| Cortical Patches | 0 | 0 | 0 | 3.6 | 3.0 | 4.6 | 5.6 | 5.6 | 6.1 | 0 | 0 | 0 | 0 | 0 | 0 |
| Bud | 0 | 0 | 0 | 0 | 0 | 0 | 0 | 3.4 | 0 | 0 | 0 | 0 | 0 | 0 | 0 |
| Bud Neck | 0 | 0 | 0 | 0 | 0 | 0 | 0 | 0 | 0 | 0 | 0 | 0 | 0 | 0 | 0 |
| Bud Site | 0 | 0 | 0 | 0 | 0 | 0 | 0 | 0 | 0 | 0 | 0 | 0 | 0 | 0 | 0 |
| Cell Periphery | 1.5 | -0.1 | 3.0 | 1.7 | 3.1 | 3.3 | 5.2 | 4.2 | 6.1 | -3.0 | -2.2 | -2.5 | -1.6 | 0 | 0 |
| Cytoplasm | -1.0 | -3.5 | -5.9 | -7.7 | -11.6 | -8.7 | -11.0 | -12.6 | -12.9 | 0.2 | 0.9 | 2.1 | 2.3 | 1.3 | 1.4 |
| Endoplasmic Reticulum | 0.1 | 4.1 | 4.6 | 7.4 | 11.1 | 6.7 | 8.4 | 7.8 | 10.1 | 0.3 | 0.1 | -2.2 | -0.5 | 0 | 0 |
| Endosome | 0 | 0 | 0 | 0 | 0 | 0 | 0 | 0 | 0 | 0 | 0 | 0 | 0 | 0 | 0 |
| Golgi | 0 | 0 | 0 | 0 | 0 | 3.3 | 0 | 3.8 | 2.6 | 0 | 0 | 0 | 0 | 0 | 0 |
| Mitochondria | 0 | 0 | 0 | 0 | 0 | 0 | 3.3 | 3.7 | 0 | 0 | 0 | 0 | 0 | 0 | 0 |
| Nucleus | 0 | 0 | 0 | 0 | 0 | 0 | 0 | 0 | 0 | 0 | 0 | 0 | 0 | 0 | 0 |
| Nuclear Periphery | 0 | 0 | 0 | 0 | 0 | 0 | 0 | 0 | 0 | 0 | 0 | 0 | 0 | 0 | 0 |
| Nucleolus | 0 | 0 | 0 | 0 | 0 | 0 | 0 | 0 | 0 | 0 | 0 | 0 | 0 | 0 | 0 |
| Peroxisomes | 0 | 0 | 0 | 0 | 0 | 0 | 0 | 0 | 0 | 0 | 0 | 0 | 0 | 0 | 0 |
| SpindlePole | 0 | 0 | 0 | 0 | 0 | 0 | 0 | 0 | 0 | 0 | 0 | 0 | 0 | 0 | 0 |
| Vacuole | 0 | 0 | 0 | 0 | 1.7 | 0 | 1.1 | 4.2 | 1.5 | 0 | 0 | 0 | 0 | 0 | 0 |
External localization resources
Images






























Protein Concentration and Protein Localization Data
| R1 | R2 | R3 | ||||||||||||||||
|---|---|---|---|---|---|---|---|---|---|---|---|---|---|---|---|---|---|---|
| G1 Pre-START | G1 Post-START | S/G2 | Metaphase | Anaphase | Telophase | G1 Pre-START | G1 Post-START | S/G2 | Metaphase | Anaphase | Telophase | G1 Pre-START | G1 Post-START | S/G2 | Metaphase | Anaphase | Telophase | |
| Concentration | 47.4938 | 68.2619 | 59.5845 | 57.5225 | 52.0618 | 62.636 | 62.9413 | 83.2471 | 76.7244 | 76.9103 | 72.9004 | 78.8943 | 62.0997 | 81.3205 | 74.2979 | 60.4248 | 62.5399 | 71.446 |
| Actin | 0.012 | 0.0001 | 0.0018 | 0.0002 | 0.0007 | 0.0007 | 0.0101 | 0.0015 | 0.0066 | 0.0001 | 0.0068 | 0.0011 | 0.0007 | 0.0003 | 0.0042 | 0.0058 | 0.0002 | 0.001 |
| Bud | 0.0011 | 0.0004 | 0.001 | 0.0011 | 0.001 | 0.0007 | 0.0008 | 0.0003 | 0.0008 | 0.0006 | 0.0008 | 0.001 | 0.0011 | 0.0005 | 0.0005 | 0.0091 | 0.0006 | 0.0003 |
| Bud Neck | 0.0019 | 0.0004 | 0.0007 | 0.0007 | 0.0006 | 0.002 | 0.0008 | 0.0005 | 0.0022 | 0.0005 | 0.0005 | 0.0012 | 0.0005 | 0.0005 | 0.0006 | 0.0011 | 0.0007 | 0.0016 |
| Bud Periphery | 0.0013 | 0.0003 | 0.0017 | 0.0005 | 0.0011 | 0.0015 | 0.0012 | 0.0002 | 0.0007 | 0.0003 | 0.0009 | 0.001 | 0.0011 | 0.0003 | 0.0004 | 0.0142 | 0.0025 | 0.0003 |
| Bud Site | 0.0021 | 0.0005 | 0.0011 | 0.0003 | 0.0001 | 0.0001 | 0.0008 | 0.0004 | 0.0008 | 0.0001 | 0.0021 | 0.0001 | 0.0006 | 0.0012 | 0.0002 | 0.011 | 0.0001 | 0.0002 |
| Cell Periphery | 0.0073 | 0.0034 | 0.0094 | 0.002 | 0.0033 | 0.0086 | 0.0097 | 0.0095 | 0.0093 | 0.0035 | 0.0008 | 0.0068 | 0.01 | 0.0064 | 0.0085 | 0.0186 | 0.0038 | 0.0042 |
| Cytoplasm | 0.6901 | 0.9574 | 0.8253 | 0.6504 | 0.8039 | 0.8942 | 0.7438 | 0.9364 | 0.8765 | 0.8623 | 0.8706 | 0.8699 | 0.8435 | 0.9443 | 0.904 | 0.7054 | 0.8403 | 0.8716 |
| Cytoplasmic Foci | 0.0114 | 0.0009 | 0.0066 | 0.0091 | 0.0044 | 0.0021 | 0.008 | 0.002 | 0.0056 | 0.0015 | 0.0135 | 0.0042 | 0.0088 | 0.0011 | 0.0037 | 0.0042 | 0.0061 | 0.0047 |
| Eisosomes | 0.0002 | 0 | 0.0002 | 0.0001 | 0.001 | 0 | 0.0002 | 0 | 0.0001 | 0 | 0.0007 | 0.0032 | 0.0001 | 0 | 0.0001 | 0.0003 | 0.0001 | 0.0002 |
| Endoplasmic Reticulum | 0.071 | 0.0097 | 0.0502 | 0.0103 | 0.0116 | 0.0246 | 0.0592 | 0.0187 | 0.0172 | 0.0045 | 0.0028 | 0.0446 | 0.0374 | 0.0122 | 0.0149 | 0.0098 | 0.014 | 0.0536 |
| Endosome | 0.0201 | 0.0017 | 0.0048 | 0.0132 | 0.0147 | 0.0051 | 0.0126 | 0.0012 | 0.0036 | 0.0046 | 0.0062 | 0.0144 | 0.0069 | 0.0018 | 0.0044 | 0.0121 | 0.0092 | 0.0105 |
| Golgi | 0.0033 | 0.0002 | 0.0008 | 0.0008 | 0.0011 | 0.0006 | 0.0021 | 0.0004 | 0.0008 | 0.0001 | 0.0016 | 0.0047 | 0.0012 | 0.0003 | 0.0008 | 0.0021 | 0.0004 | 0.0037 |
| Lipid Particles | 0.0038 | 0.0004 | 0.0046 | 0.006 | 0.0029 | 0.0004 | 0.0061 | 0.0011 | 0.0023 | 0.0003 | 0.0069 | 0.0007 | 0.0047 | 0.0006 | 0.0018 | 0.0095 | 0.0027 | 0.0026 |
| Mitochondria | 0.0043 | 0.0002 | 0.0065 | 0.0043 | 0.0468 | 0.0004 | 0.0063 | 0.0002 | 0.0018 | 0.0001 | 0.0078 | 0.0152 | 0.0023 | 0.0006 | 0.0014 | 0.0192 | 0.0021 | 0.01 |
| None | 0.0032 | 0.0001 | 0.0035 | 0.002 | 0.0051 | 0.0002 | 0.0058 | 0.0002 | 0.0012 | 0.0002 | 0.0028 | 0.0004 | 0.0023 | 0.0002 | 0.0025 | 0.0009 | 0.0095 | 0.0026 |
| Nuclear Periphery | 0.0231 | 0.0014 | 0.004 | 0.007 | 0.0063 | 0.0042 | 0.0217 | 0.0015 | 0.0036 | 0.0036 | 0.0021 | 0.003 | 0.0058 | 0.0015 | 0.0027 | 0.004 | 0.0041 | 0.0043 |
| Nucleolus | 0.0012 | 0 | 0.0008 | 0.0018 | 0.0005 | 0.0001 | 0.0058 | 0.0001 | 0.0015 | 0.0001 | 0.0013 | 0.0001 | 0.0029 | 0.0005 | 0.0007 | 0.0021 | 0.0006 | 0.001 |
| Nucleus | 0.0133 | 0.001 | 0.0023 | 0.0034 | 0.0022 | 0.0018 | 0.0073 | 0.0008 | 0.0021 | 0.0023 | 0.0018 | 0.0013 | 0.003 | 0.0021 | 0.0013 | 0.0041 | 0.0023 | 0.0031 |
| Peroxisomes | 0.0011 | 0 | 0.0011 | 0.0005 | 0.0002 | 0 | 0.0037 | 0.0017 | 0.0005 | 0 | 0.001 | 0.0001 | 0.0029 | 0 | 0.0002 | 0.0005 | 0.0002 | 0.0006 |
| Punctate Nuclear | 0.0017 | 0 | 0.0002 | 0.0001 | 0.0001 | 0 | 0.0059 | 0 | 0.0017 | 0 | 0.0042 | 0 | 0.0003 | 0.0004 | 0.0007 | 0.0002 | 0.0002 | 0.0007 |
| Vacuole | 0.1043 | 0.0207 | 0.0649 | 0.2392 | 0.0702 | 0.0434 | 0.0775 | 0.0224 | 0.0543 | 0.1052 | 0.0489 | 0.0229 | 0.0578 | 0.0237 | 0.0425 | 0.1411 | 0.0871 | 0.0195 |
| Vacuole Periphery | 0.022 | 0.0011 | 0.0083 | 0.0471 | 0.0225 | 0.0091 | 0.0105 | 0.0009 | 0.0069 | 0.01 | 0.0158 | 0.0043 | 0.0059 | 0.0015 | 0.0039 | 0.0245 | 0.0132 | 0.0038 |
Sequencing Data
| R1 | R2 | |||||||||
|---|---|---|---|---|---|---|---|---|---|---|
| G1 Post-START | S/G2 | Metaphase | Anaphase | Telophase | G1 Post-START | S/G2 | Metaphase | Anaphase | Telophase | |
| Gene Expression | 481.9289 | 450.7558 | 513.7645 | 456.0639 | 469.8084 | 450.5537 | 383.5501 | 371.6911 | 424.6298 | 405.0387 |
| Translational Efficiency | 1.5876 | 1.6087 | 1.4635 | 1.9138 | 1.7953 | 1.5263 | 1.5275 | 1.8412 | 1.5121 | 1.5945 |
Hit Data
| Dataset | Hit |
|---|---|
| Protein Concentration | ✘ |
| Protein Localization | ✘ |
| Gene Expression | ✘ |
| Translational Efficiency | ✘ |
Micrographs
































Cell Count
| R1 | R2 | R1 & R2 | |||||||||
|---|---|---|---|---|---|---|---|---|---|---|---|
| WT | UBP2 | UBP14 | UBP2UBP14 | WT | UBP2 | UBP14 | UBP2UBP14 | WT | UBP2 | UBP14 | UBP2UBP14 |
| 238 | 1321 | 1162 | 1287 | 1440 | 1889 | 130 | 1057 | 1678 | 3210 | 1292 | 2344 |
Protein Abundance
| R1 | R2 | R1 & R2 | ||||||||||
|---|---|---|---|---|---|---|---|---|---|---|---|---|
| WT | UBP2 | UBP14 | UBP2UBP14 | WT | UBP2 | UBP14 | UBP2UBP14 | WT | UBP2 | UBP14 | UBP2UBP14 | |
| Mean | 3560.49 | 4574.36 | 7170.01 | 5737.70 | 3969.87 | 4334.41 | 6945.92 | 7050.38 | 3911.81 | 4433.16 | 7147.46 | 6329.64 |
| Standard Deviation | 654.53 | 1113.92 | 1464.46 | 1671.44 | 1032.54 | 983.36 | 1237.20 | 1659.51 | 998.04 | 1045.76 | 1444.79 | 1789.54 |
| Intensity Change Log 2 | — | 0.361494 | 1.009899 | 0.688397 | — | 0.126744 | 0.807074 | 0.828609 | — | 0.242507 | 0.906533 | 0.764009 |
Localization Score (DeepLoc)
| R1 | R2 | R1 & R2 | ||||||||||
|---|---|---|---|---|---|---|---|---|---|---|---|---|
| WT | UBP2 | UBP14 | UBP2UBP14 | WT | UBP2 | UBP14 | UBP2UBP14 | WT | UBP2 | UBP14 | UBP2UBP14 | |
| Actin | 0.000148 | 0.000185 | 0.000110 | 0.000359 | 0.000074 | 0.000077 | 0.000203 | 0.000250 | 0.000085 | 0.000122 | 0.000119 | 0.000309 |
| Bud Neck | 0.000848 | 0.000568 | 0.002656 | 0.003016 | 0.000349 | 0.000333 | 0.006844 | 0.001925 | 0.000420 | 0.000430 | 0.003078 | 0.002524 |
| Bud Site | 0.010298 | 0.003374 | 0.003616 | 0.010546 | 0.003127 | 0.003487 | 0.006442 | 0.010128 | 0.004145 | 0.003441 | 0.003901 | 0.010357 |
| Cell Periphery | 0.043052 | 0.013650 | 0.011530 | 0.023397 | 0.012792 | 0.007711 | 0.050325 | 0.039316 | 0.017084 | 0.010155 | 0.015433 | 0.030575 |
| Cytoplasm | 0.564111* | 0.712530* | 0.620266* | 0.559804* | 0.777963* | 0.860843* | 0.236001* | 0.591958* | 0.747631* | 0.799808* | 0.581602* | 0.574303* |
| Cytoplasmic Foci | 0.018711 | 0.010102 | 0.008031 | 0.006633 | 0.007158 | 0.008665 | 0.020519 | 0.006639 | 0.008797 | 0.009256 | 0.009288 | 0.006635 |
| Eisosomes | 0.000004 | 0.000002 | 0.000002 | 0.000006 | 0.000001 | 0.000001 | 0.000012 | 0.000005 | 0.000002 | 0.000002 | 0.000003 | 0.000006 |
| Endoplasmic Reticulum | 0.002093 | 0.001125 | 0.000421 | 0.000423 | 0.001120 | 0.000552 | 0.000307 | 0.000360 | 0.001258 | 0.000788 | 0.000410 | 0.000394 |
| Endosome | 0.001858 | 0.000895 | 0.000614 | 0.003532 | 0.000720 | 0.000558 | 0.001034 | 0.000819 | 0.000882 | 0.000697 | 0.000656 | 0.002308 |
| Golgi | 0.123817* | 0.075983 | 0.028705 | 0.012908 | 0.056448 | 0.035751 | 0.034366 | 0.019503 | 0.066003 | 0.052308 | 0.029275 | 0.015882 |
| Lipid Particles | 0.030195 | 0.009534 | 0.008216 | 0.015594 | 0.014774 | 0.007991 | 0.041482 | 0.033653 | 0.016961 | 0.008626 | 0.011563 | 0.023737 |
| Mitochondria | 0.000303 | 0.000243 | 0.000249 | 0.002450 | 0.000096 | 0.000189 | 0.000096 | 0.000317 | 0.000126 | 0.000211 | 0.000234 | 0.001488 |
| Mitotic Spindle | 0.001575 | 0.001810 | 0.001448 | 0.004618 | 0.000871 | 0.001104 | 0.003346 | 0.000834 | 0.000971 | 0.001395 | 0.001639 | 0.002912 |
| None | 0.001443 | 0.001602 | 0.001624 | 0.002458 | 0.002382 | 0.001977 | 0.000694 | 0.001447 | 0.002249 | 0.001823 | 0.001530 | 0.002002 |
| Nuclear Periphery | 0.000483 | 0.000562 | 0.001753 | 0.000497 | 0.000355 | 0.000233 | 0.002840 | 0.000497 | 0.000373 | 0.000369 | 0.001863 | 0.000497 |
| Nuclear Periphery Foci | 0.012555 | 0.012296 | 0.011674 | 0.005433 | 0.010578 | 0.006800 | 0.016800 | 0.006943 | 0.010858 | 0.009062 | 0.012189 | 0.006114 |
| Nucleolus | 0.000146 | 0.000062 | 0.000197 | 0.000370 | 0.000112 | 0.000043 | 0.000175 | 0.000181 | 0.000117 | 0.000051 | 0.000195 | 0.000285 |
| Nucleus | 0.004231 | 0.006965 | 0.022674 | 0.027094 | 0.007514 | 0.004927 | 0.019303 | 0.011808 | 0.007048 | 0.005766 | 0.022335 | 0.020201 |
| Peroxisomes | 0.000091 | 0.000016 | 0.000030 | 0.000436 | 0.000037 | 0.000024 | 0.000023 | 0.000071 | 0.000045 | 0.000020 | 0.000030 | 0.000272 |
| Vacuole | 0.076640 | 0.067331 | 0.209364* | 0.294533* | 0.055097 | 0.030142 | 0.510480* | 0.248296* | 0.058153 | 0.045446 | 0.239662* | 0.273683* |
| Vacuole Periphery | 0.107396* | 0.081164 | 0.066818 | 0.025894 | 0.048431 | 0.028590 | 0.048708 | 0.025049 | 0.056794 | 0.050226 | 0.064996 | 0.025513 |
Localization Changes (T-score)
| R1 | R2 | R1 & R2 | |||||||||||||
|---|---|---|---|---|---|---|---|---|---|---|---|---|---|---|---|
| UBP2_WT | UBP14_WT | UBP2UBP14_WT | UBP2UBP14_UBP2 | UBP2UBP14_UBP14 | UBP2_WT | UBP14_WT | UBP2UBP14_WT | UBP2UBP14_UBP2 | UBP2UBP14_UBP14 | UBP2_WT | UBP14_WT | UBP2UBP14_WT | UBP2UBP14_UBP2 | UBP2UBP14_UBP14 | |
| Actin | -0.42 | -0.28 | -3.12 | -1.46 | -3.26 | -0.44 | -5.06 | -6.00 | -5.86 | -1.47 | -1.01 | -5.28 | -6.81 | -4.00 | -4.41 |
| Bud Neck | 0.98 | -6.07 | -7.94 | -10.63 | 0.11 | 0.10 | -7.32 | -8.47 | -8.49 | 5.46 | -0.45 | -9.27 | -13.69 | -13.68 | 2.65 |
| Bud Site | 3.57 | 2.96 | -0.55 | -6.47 | -5.43 | -0.82 | -2.94 | -6.09 | -5.84 | -2.58 | 1.46 | -0.95 | -7.56 | -8.72 | -6.78 |
| Cell Periphery | 5.79 | 6.31 | 5.00 | -1.89 | -3.40 | 4.50 | -4.31 | -9.84 | -12.60 | 0.75 | 5.59 | 1.83 | -5.10 | -11.14 | -6.87 |
| Cytoplasm | -5.80 | -0.76 | 0.52 | 12.41 | 2.35 | -8.77 | 20.07 | 14.87 | 23.30 | -12.19 | -5.61 | 15.58 | 17.61 | 27.15 | -1.20 |
| Cytoplasmic Foci | 3.16 | 3.21 | 4.34 | 3.45 | 2.61 | -2.14 | -4.47 | -0.10 | 1.96 | 4.44 | -0.75 | -2.42 | 2.28 | 3.71 | 4.32 |
| Eisosomes | 2.14 | 0.72 | -2.53 | -4.25 | -3.47 | 1.41 | -6.33 | -9.20 | -9.70 | 3.52 | 0.36 | -8.05 | -9.54 | -8.94 | -3.12 |
| Endoplasmic Reticulum | 2.27 | 4.88 | 5.07 | 3.28 | 1.18 | 1.83 | 2.73 | 2.55 | 3.06 | -0.91 | 1.62 | 3.26 | 3.46 | 4.20 | 1.14 |
| Endosome | 4.52 | 5.89 | -1.38 | -3.00 | -3.36 | 2.15 | -3.01 | -1.01 | -2.31 | 1.60 | 2.40 | 1.89 | -2.95 | -3.49 | -3.37 |
| Golgi | 4.56 | 9.63 | 11.37 | 19.96 | 11.50 | 6.40 | 6.47 | 13.32 | 8.59 | 3.49 | 4.19 | 12.96 | 18.47 | 21.03 | 10.26 |
| Lipid Particles | 5.08 | 5.31 | 4.12 | -2.93 | -3.88 | 4.96 | -4.52 | -7.87 | -11.80 | 1.01 | 6.53 | 3.67 | -3.31 | -11.34 | -7.85 |
| Mitochondria | 0.62 | 0.16 | -1.89 | -2.01 | -1.94 | -3.60 | -1.47 | -2.91 | -1.84 | -2.53 | -3.03 | -4.33 | -2.43 | -2.21 | -2.05 |
| Mitotic Spindle | -0.71 | -0.29 | -2.21 | -1.80 | -2.15 | -1.10 | -2.56 | -0.01 | 0.95 | 2.55 | -2.00 | -4.11 | -2.63 | -1.81 | -1.18 |
| None | -0.69 | -0.52 | -1.62 | -1.38 | -1.35 | 0.76 | 4.72 | 1.48 | 0.80 | -2.15 | 1.12 | 2.27 | 0.85 | -0.17 | -1.28 |
| Nuclear Periphery | -1.05 | -5.73 | 0.06 | 1.11 | 5.74 | 3.71 | -6.51 | -4.40 | -8.07 | 6.11 | -0.05 | -7.38 | -2.66 | -2.63 | 6.78 |
| Nuclear Periphery Foci | 0.07 | 0.22 | 4.80 | 8.73 | 7.32 | 5.10 | -3.08 | 5.40 | -0.22 | 4.93 | 2.58 | -1.84 | 8.45 | 6.32 | 7.75 |
| Nucleolus | 1.01 | -0.83 | -2.07 | -9.86 | -3.01 | 1.73 | -1.94 | -1.66 | -3.80 | 0.01 | 1.85 | -2.76 | -4.02 | -9.45 | -1.55 |
| Nucleus | -1.85 | -10.87 | -13.31 | -13.22 | -2.91 | 2.48 | -4.03 | -5.54 | -7.65 | 2.34 | 1.30 | -11.34 | -13.74 | -15.29 | 0.58 |
| Peroxisomes | 2.55 | 1.99 | -1.00 | -1.37 | -1.30 | 1.45 | 1.33 | -2.69 | -5.67 | -5.35 | 2.76 | 1.35 | -1.32 | -1.53 | -1.44 |
| Vacuole | 0.94 | -13.78 | -19.41 | -26.23 | -5.90 | 7.40 | -16.11 | -22.70 | -26.49 | 8.51 | 3.87 | -23.82 | -34.11 | -38.17 | -2.06 |
| Vacuole Periphery | 2.41 | 4.23 | 8.39 | 15.76 | 12.87 | 6.04 | 1.09 | 8.06 | 2.61 | 3.27 | 1.91 | -0.79 | 11.69 | 13.84 | 13.30 |
Endocytosis
| Temp | Actin Patch (Sac6-tdTomato) | Cortical Patch (Sla1-GFP) | Late Endosome (Snf7-GFP) | Vacuole (Vph1-GFP) |
|---|---|---|---|---|
| 37℃ | ||||
| RT |
Cell Cycle Omics
CYCLoPs (Gus1-GFP)
| Gene / Allele | Actin Patch (Sac6-tdTomato) | Cortical Patch (Sla1-GFP) | Late Endosome (Snf7-GFP) | Vacuole (Sac6-tdTomato) |
|---|
| Gene | Images |
|---|
| Gene | Images |
|---|
Images are not yet available
Images are not yet available